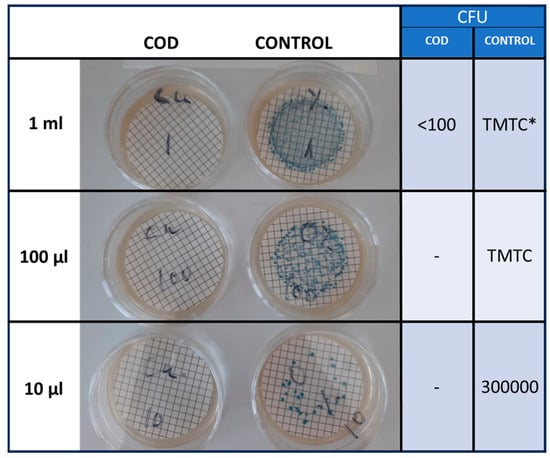

Abstract
Microbial infections in wounds can significantly delay the healing process, with bacteria often forming protective biofilms that shield them from external threats. In this study, we evaluated the impact of copper oxide-impregnated wound dressings (referred to as COD) on a bacterial mixture comprising common Gram-positive and Gram-negative wound pathogens encased in biofilm. The bacterial mix was exposed to COD or control dressings for 0, 1, 2, and 3 h, and the effects were analyzed using scanning electron microscopy. After just 1 h of exposure to COD, notable leakage of bacterial cytoplasmic contents was observed. By the 3 h mark, the Gram-negative bacteria exhibited a formation of holes in their cell walls, while Gram-positive bacteria showed a reduction in cell width. These findings demonstrate the ability of COD to effectively kill bacteria even when protected by biofilm, supporting clinical observations of its efficacy in managing infected wounds.
1. Introduction
The infection of wounds delays healing through several mechanisms: release of harmful enzymes and radicals by activated neutrophils, buildup of metabolic waste, tissue hypoxia, fragile granulation tissue, decreased fibroblast numbers, reduced collagen production, and impaired reepithelialization [1,2]. Bacteria contaminating the wounds often form biofilms that protect them from the immune system and antibiotics, which enhances their survival and pathogenicity, promotes development of microbial resistance to treatment, and delays wound healing, leading to wound chronicity [1,2,3]. Bacterial biofilm formation is a structured, multi-stage process where bacteria adhere to surfaces, grow, and develop into organized communities within an extracellular matrix. Initially, bacteria attach reversibly to surfaces through appendages like pili or flagella, influenced by environmental and surface conditions. This is followed by irreversible attachment, during which cells produce an extracellular polymeric substance (EPS) matrix, securing them firmly. In the maturation stage, biofilms grow in complexity, with cells communicating through quorum sensing to form 3D structures with channels for nutrient and waste flow. Finally, in the dispersion phase, cells are released from the biofilm to colonize new surfaces, aiding in biofilm spread and survival across diverse environments [4,5]. Microbial wound infection causes a significant burden to patients and to the health care systems [6,7], especially with the surge of antibiotic resistant microorganisms. Reducing microbial contamination enhances wound healing [8].
Copper, and cuprous oxide in particular, have wide spectrum potent inherent antimicrobial properties [9,10,11]. Previously we have described the in vitro potent wide spectrum antimicrobial efficacy of copper oxide microparticles impregnated dressings [12], hereafter termed COD. The COD are in clinical use for the management of acute and chronic wounds since 2020. Studies conducted with the COD demonstrated the capacity of the COD to stimulate wound healing, even of hard-to-heal chronic wounds that did not respond favorably to other wound management interventions [13,14,15,16,17,18,19]. In the current study, we analyzed the morphological effects of the COD on Gram-positive and Gram-negative bacteria exposed to the dressings by using scanning electron microscopy analyses.
2. Materials and Methods
COD (Figure 1), described previously [12], and wound dressings without copper with a similar polymer component content and construction (3M Life Sterile Dressings; Hubei Qianjiang Kingphur Medical Materials Co., Ltd., Qianjiang, China), were used as test and control dressings, respectively.

Figure 1.
Cuprous oxide microparticles impregnated wound dressings (COD). (a) The COD are composed of one or two external non-adherent orange-colored layers and a highly absorbent beige-colored layer that can absorb ~10 times its own weight. The dressings are provided with or without an adhesive contour. The cuprous oxide impregnated microparticles are the white dots seen in the scanning electronic microscopy images of the orange layer (b) and the absorbent layer (c).
A bacterial mix was prepared from the following organisms: Methicillin resistant Staphylococcus aureus (MRSA; ATCC BAA-1708); Escherichia coli (ATCC 8739); Klebsiella pneumoniae (ATCC 4352); and Enterococcus faecalis (ATCC 19439). Each microorganism was grown overnight at 37 ± 2 °C in Tryptic soy broth (TBS; Hy laboratories Ltd., Rehovot, Israel). Then 10 µL of each of the overnight cultures were mixed in 1 mL of TBS and grown at 37 ± 2 °C for 4–24 h, in replicates, followed by centrifugation. The pellets were resuspended in 600 µL of 0.85% saline/0.1% Tween 80 (ST; Sigma Aldrich Israel Ltd. 3 Prof. M. Flaut, Rehovot 7670603, Israel).
The formation of biofilm was confirmed by Crystal violet (CV) staining. Briefly, 100 µL aliquots of the bacterial suspension were inoculated into a 96-well plate and incubated for 4, 6, 8, 16, and 24 h at 37 °C. The TSB was carefully discarded to remove planktonic cells, the wells were rinsed gently 3 times with phosphate-buffered saline (PBS) to remove any remaining non-adherent cells. Then 100 µL of 1% CV solution (Sigma-Aldrich) were added to each well covering the biofilm completely. After 15 min incubation at room temperature the CV solution was removed, and the wells were rinsed 3 times with PBS to remove excess stain. After letting the plate to air-dry, 100 µL of ethanol was added to each well to solubilize the CV stain bound to the biofilm. The absorbance at 570 nm was determined using a microplate reader to quantify the biofilm biomass indirectly [20].
Scanning electron microscopy analysis was conducted with the stock bacterial mix (SBM) grown at 37 ± 2 °C for 7 h, during the microbial logarithmic growth phase, resuspended to a concentration of ~109 CFU/mL. Duplicate 0.5 cm × 0.5 cm square swatches from each test and control wound dressing were aseptically cut and each individual swatch was put in an Eppendorf tube. Fifty µL of the SBM were added to each swatch, making sure that all liquid was completely absorbed by the control and test swatch samples. The swatches were then incubated at 37 ± 2 °C for 0, 1, 2 or 3 h.
For bacterial viability determination following exposure to the dressings, duplicate sterile swatches of the control and test samples were transferred to containers with 100 mL of neutralizing solution (DeyEngley (D/E) Broth; LAB187, Lab M Limited, Heywood, UK), then to sterile stomager bags (Alex Red Ltd. Mevasseret Zion, 9140002, Israel). The bags were stomached for 2 min and 10 µL, 100 µL, and 1 mL of each liquid were filtered through 0.45 µm Cellulose Nitrate Filters (Sartorious Stedim Biotech GmbH, Goettingen 37079, Germany) by using a Pall filtration device (Pall Corporation, Port Washington, New York, 11050, USA). The filters were rinsed twice with 100 ± 5 mL of ST and then incubated on CHROMagar™ Orientation agar (http://www.chromagar.com, accessed on 5 January 2024) at 37 ± 2 °C for 24 h. Colony Forming Units (CFU) were then counted. The percent of bacterial reduction was determined as previously published [12] according to the following formula: 100(A−B)/A = % reduction; A = organism population of the bacterial mix challenge; B = the number of test organisms recovered from the inoculated test sample.
For morphological analysis of the bacteria exposed to the dressings, 1 mL of ST was added to the remaining swatches, and bacteria were recovered by 3 min of centrifugation at 1200 rpm. The swatches were removed and the bacterial pellets were transferred to circular glass coverslips placed in a 96-well plate and pretreated with 0.01% poly-l-lysine (Sigma-Aldrich Chemie Gmbh, St. Louis, MO 63103, USA) for 60 min in order to attach the bacteria to the plates. The bacteria were then fixed with 2% glutaraldehyde and 2% formaldehyde in 0.1 M phosphate buffer (pH 7.2) for 1 h at room temperature. The fixatives were rinsed out by 3 consecutive washes every 10 min with 200 µL 0.1 M phosphate buffer (pH 7.2). The bacteria were then dehydrated by exposing them to increasing ethanol concentrations (20%, 50% 70%, 90%, 95%) each twice for 10 min and finally in 100% ethanol concentration four times for 10 min. The samples were then dried in a Critical Point Dryer (Quorum, K850) in which the ethanol was replaced by liquid CO2 at 5 °C, followed by heating at 36 °C, so the liquid CO2 transitions to gas and was released slowly, leaving the samples dry. Then the samples were sputter-coated with gold-palladium (Quorum, Q150T ES).
The samples were examined by a scanning electron microscope (JEOL model JSM-7800F for high resolution or IT-100 for standard). The images were taken with an accelerating voltage of 1–2 kV for high resolution and 20 kV for standard. Bacteria length and width were measured based on the electron microscope scaler.
Statistical Analysis
To investigate the effect of COD on the average width and length of the bacteria, three repeated experiments were performed. We conducted t-tests on the size measurements. Prior to analysis, we checked the assumptions of the t-test, including normality and equal variances.
The statistical differences between the microbial titers obtained at each time point between the COD and the negative control dressing were examined using t-tests.
A significance level of 0.05 was selected to determine statistical significance, and all tests were two-sided. Analyses were performed using JMP® Pro, Version 16.
3. Results
The bacterial mix grown for 7 to 24 h at 37 ± 2 °C were viable and produced biofilm, as confirmed by Crystal violate staining. As can be seen in Figure 2, a plateau was reached after 8 h of incubation. We decided to use for further analysis bacterial mix grown for 7 h (Figure 3a), during the logarithmic growth phase of the bacteria, since at longer incubation periods bacterial cell damage started to occur in the control samples. The exposure of the bacterial mix to the COD and their immediate recovery by centrifugation (Time 0) did not have a visible effect on the bacteria (Figure 3b).

Figure 2.
The bacterial mix was grown at 37 ± 2 °C for 4, 6, 8, 16, and 24 h. Crystal violate staining was then performed to confirm biofilm formation. The results shown are mean and SD of triplicate samples.

Figure 3.
(a). Bacterial mix grown for 7 h at 37 ± 2 °C. (b). Bacterial mix grown for 7 h at 37 ± 2 °C, inoculated and immediately recovered from the COD (Time 0). Notice the biofilm covering the bacterial mix.
In contrast, exposure of the bacterial mix to the COD for 1 h resulted in secretion of bacterial cytoplasmic content, as shown in some representative Scanning Electron Microscopy (SEM) pictures in Figure 4.

Figure 4.
Representative SEM pictures of the bacterial mix exposed for 1 h at 37 ± 2 °C to the COD. Notice the secretion of the cytoplasmic content from the bacteria (some marked with arrows).
Accordingly, there was more than 99% reduction (p < 0.001) in the viable bacterial titers as compared to the control dressings (Figure 5).
Figure 5.
COD and control dressings were inoculated with ~106 CFU of the SBM and incubated for 1 h at 37 ± 2 °C. After the incubation, the bacteria were recovered by filtering 10 μL, 100 μL, and 1 mL of the 100 mL stomached microbial solution. The CFU of the surviving bacteria were then determined after 24 h of incubation at 37 ± 2 °C. Representative examples of the CFU obtained from a COD swatch and a control dressing swatch are shown. * Too many to count.
Two hours exposure of the bacteria to the COD resulted in similar extracellular content secretion by the bacteria (Figure 6), with more than 99% reduction (p < 0.001) in the bacterial viability.

Figure 6.
Representative SEM pictures of the bacterial mix exposed for 2 h at 37 ± 2 °C to the control dressing (a) and COD (b–d). Notice the secretion of the cytoplasmic content from the bacteria exposed to the COD.
A longer exposure of 3 h of the bacteria to the COD resulted also in the clear appearance of holes in the Gram-negative bacteria (Figure 7), but not visible in the Gram-positive bacteria. However, in the Gram-positive bacteria, the measurement of the width and length of the bacteria, as shown in a representative example in Figure 8, showed a statistically significant reduction (p < 0.001) in the width, but not in the length of the bacteria that were exposed to the COD as compared to the bacteria exposed to the control dressings (Table 1).

Figure 7.
Representative SEM pictures of the bacterial mix exposed for 3 h at 37 ± 2 °C to the COD. Notice the appearance of holes in the Gram-negative bacteria (some marked with arrows).

Figure 8.
Representative SEM picture of a Gram-positive bacterial exposed for 3 h at 37 ± 2 °C to the COD. The width and length were measured in accordance to the ruler size indicating 100 nm.

Table 1.
Measurement of the width of the bacteria following 3 h of exposure to COD or control dressings.
4. Discussion
The COD possess potent antimicrobial efficacy, as previously demonstrated [12]. In the current study, we used scanning electron microscopy analyses to study the effect that the COD have on the bacteria exposed to it. We used a mixture of known wound Gram-positive and Gram-negative bacterial pathogens [3], including of an antibiotic resistant bacterium (MRSA), to more closely imitate the natural scenario in which a wound is exposed and colonized at any given time by a mixture of bacteria [3,21]. Furthermore, as bacterial biofilms are common in chronic wounds where they impede the wound healing process [22], we grew the mix of bacteria for 7 h at 37 ± 2 °C in a rich culture medium to allow the bacteria mix to form biofilm, as shown in Figure 3, before exposing them to the COD.
As demonstrated before [12] and as confirmed in this study, exposure of the bacteria to the COD, even for 1 h, reduces their viability by more than 99%. The COD are impregnated with copper oxide microparticles that are not released from the dressing. This was demonstrated as part of the biocompatibility required studies performed in order to obtain the clearance from the regulatory bodies (unpublished data). The microparticles serve as a reservoir of copper ions. These ions are slowly and constantly released in the presence of humidity [16], endowing the wound dressing with prolonged and stable biocidal properties for at least 7 consecutive days that protect the dressings from bio-contamination and reduction of passage of viable microorganism through them from the exterior environment into the wound bed.
We found that the effect of the dressing on the bacteria included the disruption of the bacterial cell membrane, causing the leakage of cellular content, as clearly seen after 1 and 2 h of the bacterial exposure to the COD. After 3 h of exposure of the bacteria to the COD, holes were observed in the Gram-negative bacteria, but not in the Gram-positive bacteria. The positively charged copper ions can directly interact with the negatively charged bacterial cell membranes resulting in membrane depolarization. This may lead to membrane leakage and cell rupture. The possible explanation for the observed variation between the Gram-positive and Gram-negative bacteria is the difference composition and structure of their cell wall. The Gram-negative bacteria have a thin peptidoglycan layer (2–7 nm) situated between an inner cell membrane and an outer lipid-rich membrane. The Gram-positive bacteria have a thick, multi-layered peptidoglycan layer (20–80 nm) outside the cell membrane that may be more resistant to breaking up due to the exposure to the copper ions. It was clear from the antimicrobial assays that more than 99% of the bacteria were already killed after 1 h of exposure. Therefore, further, probably internal, damage was occurring in the bacteria that cannot be detected by the SEM analysis. We intend to perform a subsequent study to study the kill mechanism by conducting transmission electron microscopy (TEM) analysis at shorter periods of exposure to the dressings. The cellular secreted content was almost not seen any more at 3 h of exposure; apparently most of it was completely detached from the bacteria and washed away during the centrifugation steps. We could not clearly distinguish between MRSA and the enterococcus bacteria. We thus measured the width and length of the Gram-positive bacteria as a group and found a statistically significant reduction in the width of the Gram-positive bacteria. We did not notice a reduction in the length of the Gram-positive bacteria. Bacterial width is generally more stable and less influenced by the bacterial cell cycle, making it a more reliable metric for comparative studies between treatments. Measuring width can help minimize variability due to natural growth processes and focus more on the effects of the treatments being studied. Similar observations were found with copper-based metal–organic frameworks against Escherichia coli, Staphylococcus aureus and Lactobacillus [23,24]. The release of the internal content of bacteria when exposed to copper ions is similar to what has been described for silver nanoparticles [25].
The capacity of copper nanoparticles to inhibit the formation of biofilm was demonstrated [26,27]. However, bacteria in wounds are in many cases already covered by biofilm when covered with wound dressings. Importantly, in the current study, we demonstrate that the bacteria are killed even when they are already covered by biofilm. However, this study was performed under laboratory-controlled conditions. While the capacity of the dressings to reduce bioburden in an infected diabetic foot ulcer was already shown using real-time fluorescence imaging device [28], specific wound conditions and environmental factors may influence the performance of the COD. Additional real-life studies should be conducted to further determine the capacity of the COD to kill bacteria covered by biofilm in wounds. Our findings are in accordance with previous studies that demonstrated the capacity of copper nanoparticles and other nanoparticles to have an antimicrobial effect on biofilms, through the generation of reactive oxygen species [29], and are in accordance with clinical observation of management of wound infection in acute and chronic wounds by the COD [13,16,18].
5. Conclusions
The current study demonstrates the capacity of COD to kill bacteria even when they are already covered by biofilm. It shows that part of the killing mechanism is through the damage of the bacterial cell wall of the bacteria exposed to the dressings, leading to the secretion of the cytoplasmic content from the bacteria. Further studies are needed to determine if the bacteria are killed when exposed to the copper ions even before the loss of the cytoplasmic content occurs.
Author Contributions
G.B., T.R. and E.Z. designed the studies. T.R. performed the experiments, and T.R., E.Z. and T.K. performed the microscopy analyses. All authors contributed to the writing of the article. All authors have read and agreed to the published version of the manuscript.
Funding
This research was funded by MedCu Technologies Ltd.
Institutional Review Board Statement
Not applicable.
Informed Consent Statement
Not applicable.
Data Availability Statement
The raw data supporting the conclusions of this article will be made available by the authors on request.
Conflicts of Interest
G.B. is the Chief Scientist of MedCu. T.R. is a current employee of MedCu. MedCu is the company that developed the COD. E.Z. and T.K. have no conflicts of interests.
References
- Uberoi, A.; McCready-Vangi, A.; Grice, E.A. The wound microbiota: Microbial mechanisms of impaired wound healing and infection. Nat. Rev. Microbiol. 2024, 22, 507–521. [Google Scholar] [CrossRef] [PubMed]
- Maheswary, T.; Nurul, A.A.; Fauzi, M.B. The Insights of Microbes’ Roles in Wound Healing: A Comprehensive Review. Pharmaceutics 2021, 13, 981. [Google Scholar] [CrossRef]
- Rahim, K.; Saleha, S.; Zhu, X.; Huo, L.; Basit, A.; Franco, O.L. Bacterial Contribution in Chronicity of Wounds. Microb. Ecol. 2017, 73, 710–721. [Google Scholar] [CrossRef] [PubMed]
- Flemming, H.C.; Wingender, J.; Szewzyk, U.; Steinberg, P.; Rice, S.A.; Kjelleberg, S. Biofilms: An emergent form of bacterial life. Nat. Rev. Microbiol. 2016, 14, 563–575. [Google Scholar] [CrossRef] [PubMed]
- Hall-Stoodley, L.; Costerton, J.W.; Stoodley, P. Bacterial biofilms: From the natural environment to infectious diseases. Nat. Rev. Microbiol. 2004, 2, 95–108. [Google Scholar] [CrossRef] [PubMed]
- Badia, J.M.; Casey, A.L.; Petrosillo, N.; Hudson, P.M.; Mitchell, S.A.; Crosby, C. Impact of surgical site infection on healthcare costs and patient outcomes: A systematic review in six European countries. J. Hosp. Infect. 2017, 96, 1–15. [Google Scholar] [CrossRef]
- Xu, Z.; Hsia, H.C. The Impact of Microbial Communities on Wound Healing: A Review. Ann. Plast. Surg. 2018, 81, 113–123. [Google Scholar] [CrossRef]
- Anjana, J.; Rajan, V.K.; Biswas, R.; Jayakumar, R. Controlled Delivery of Bioactive Molecules for the Treatment of Chronic Wounds. Curr. Pharm. Des. 2017, 23, 3529–3537. [Google Scholar] [CrossRef]
- Borkow, G. Using copper to fight microorganisms. Curr. Chem. Biol. 2012, 6, 93–103. [Google Scholar] [CrossRef]
- Borkow, G.; Salvatori, R.; Kanmukhla, V.K. Drastic Reduction of Bacterial, Fungal and Viral Pathogen Titers by Cuprous Oxide Impregnated Medical Textiles. J. Funct. Biomater. 2021, 12, 9. [Google Scholar] [CrossRef]
- Borkow, G.; Sidwell, R.W.; Smee, D.F.; Barnard, D.L.; Morrey, J.D.; Lara-Villegas, H.H.; Shemer-Avni, Y.; Gabbay, J. Neutralizing viruses in suspensions by copper oxide based filters. Antimicrob. Agents Chemother. 2007, 51, 2605–2607. [Google Scholar] [CrossRef] [PubMed]
- Borkow, G.; Roth, T.; Kalinkovich, A. Wide spectrum potent antimicrobial efficacy of wound dressings impregnated with cuprous oxide microparticles. Microbiol. Res. 2022, 13, 366–376. [Google Scholar] [CrossRef]
- Borkow, G.; Melamed, E. Copper, an abandoned player returning to the wound healing battle. In Recent Advances in Wound Healing, 1st ed.; Shahin, A., Ed.; IntechOpen: London, UK, 2021; pp. 165–184. [Google Scholar]
- Gorel, O.; Hamuda, M.; Feldman, I.; Kucyn-Gabovich, I. Enhanced healing of wounds that responded poorly to silver dressing by copper wound dressings: Prospective single arm treatment study. Health Sci. Rep. 2024, 7, e1816. [Google Scholar] [CrossRef] [PubMed]
- Melamed, E.; Borkow, G. Continuum of care in hard-to-heal wounds by copper dressings: A case series. J. Wound Care 2023, 32, 788–796. [Google Scholar] [CrossRef]
- Melamed, E.; Kiambi, P.; Okoth, D.; Honigber, I.; Tamir, E.; Borkow, G. Healing of Chronic Wounds by Copper Oxide-Impregnated Wound Dressings-Case Series. Medicina 2021, 57, 296. [Google Scholar] [CrossRef]
- Melamed, E.; Rovitsky, A.; Roth, T.; Assa, L.; Borkow, G. Stimulation of Healing of Non-Infected Stagnated Diabetic Wounds by Copper Oxide-Impregnated Wound Dressings. Medicina 2021, 57, 1129. [Google Scholar] [CrossRef]
- Melamed, E.; Rovitsky, A.; Roth, T.; Borkow, G. Anterior ankle full thickness skin necrosis treated with copper oxide dressings without debridment and skin graft a case report. Arch. Clin. Med. Case Rep. 1980, 6, 501–510. [Google Scholar]
- Weitman, C.C.; Roth, T.; Borkow, G. Copper dressings to the wound rescue after everything else failed: Case report. Arch. Clin. Med. Case Rep. 2022, 6, 466–473. [Google Scholar]
- Stepanovic, S.; Vukovic, D.; Dakic, I.; Savic, B.; Svabic-Vlahovic, M. A modified microtiter-plate test for quantification of staphylococcal biofilm formation. J. Microbiol. Methods 2000, 40, 175–179. [Google Scholar] [CrossRef]
- Wong, S.Y.; Manikam, R.; Muniandy, S. Prevalence and antibiotic susceptibility of bacteria from acute and chronic wounds in Malaysian subjects. J. Infect. Dev. Ctries. 2015, 9, 936–944. [Google Scholar] [CrossRef]
- Cavallo, I.; Sivori, F.; Mastrofrancesco, A.; Abril, E.; Pontone, M.; Di Domenico, E.G.; Pimpinelli, F. Bacterial Biofilm in Chronic Wounds and Possible Therapeutic Approaches. Biology 2024, 13, 109. [Google Scholar] [CrossRef] [PubMed]
- Elmehrath, S.; Ahsan, K.; Munawar, N.; Alzamly, A.; Nguyen, H.L.; Greish, Y. Antibacterial efficacy of copper-based metal-organic frameworks against Escherichia coli and Lactobacillus. RSC Adv. 2024, 14, 15821–15831. [Google Scholar] [CrossRef] [PubMed]
- Zhang, H.; Bai, J.; Chen, X.; Wang, L.; Peng, W.; Zhao, Y.; Weng, J.; Zhi, W.; Wang, J.; Zhang, K.; et al. Constructing a highly efficient multifunctional carbon quantum dot platform for the treatment of infectious wounds. Regen. Biomater. 2024, 11, rbae105. [Google Scholar] [CrossRef]
- Gopinath, V.; Priyadarshini, S.; Loke, M.F.; Jagadheesan, A.; Marsili, E.; MubarakAli, D.; Velusamy, P.; Vadivelu, J. Biogenic synthesis, characterization of antibacterial silver nanoparticles and its cell cytotoxicity. Arab. J. Chem. 2017, 10, 1107. [Google Scholar] [CrossRef]
- Ahire, J.J.; Hattingh, M.; Neveling, D.P.; Dicks, L.M. Copper-Containing Anti-Biofilm Nanofiber Scaffolds as a Wound Dressing Material. PLoS ONE 2016, 11, e0152755. [Google Scholar] [CrossRef] [PubMed]
- Shehabeldine, A.M.; Amin, B.H.; Hagras, F.A.; Ramadan, A.A.; Kamel, M.R.; Ahmed, M.A.; Atia, K.H.; Salem, S.S. Potential Antimicrobial and Antibiofilm Properties of Copper Oxide Nanoparticles: Time-Kill Kinetic Essay and Ultrastructure of Pathogenic Bacterial Cells. Appl. Biochem. Biotechnol. 2023, 195, 467–485. [Google Scholar] [CrossRef]
- Lu, W.; Rao, A.; Oropallo, A.; Gawlik, S.; Haight, J. Use of Copper Nanoparticles to Reduce Bioburden in the Treatment of Diabetic Foot Ulcers. Eplasty 2022, 22, QA4. [Google Scholar]
- Nowak, M.; Baranska-Rybak, W. Nanomaterials as a Successor of Antibiotics in Antibiotic-Resistant, Biofilm Infected Wounds? Antibiotics 2021, 10, 941. [Google Scholar] [CrossRef]
Disclaimer/Publisher’s Note: The statements, opinions and data contained in all publications are solely those of the individual author(s) and contributor(s) and not of MDPI and/or the editor(s). MDPI and/or the editor(s) disclaim responsibility for any injury to people or property resulting from any ideas, methods, instructions or products referred to in the content. |
© 2024 by the authors. Licensee MDPI, Basel, Switzerland. This article is an open access article distributed under the terms and conditions of the Creative Commons Attribution (CC BY) license (https://creativecommons.org/licenses/by/4.0/).